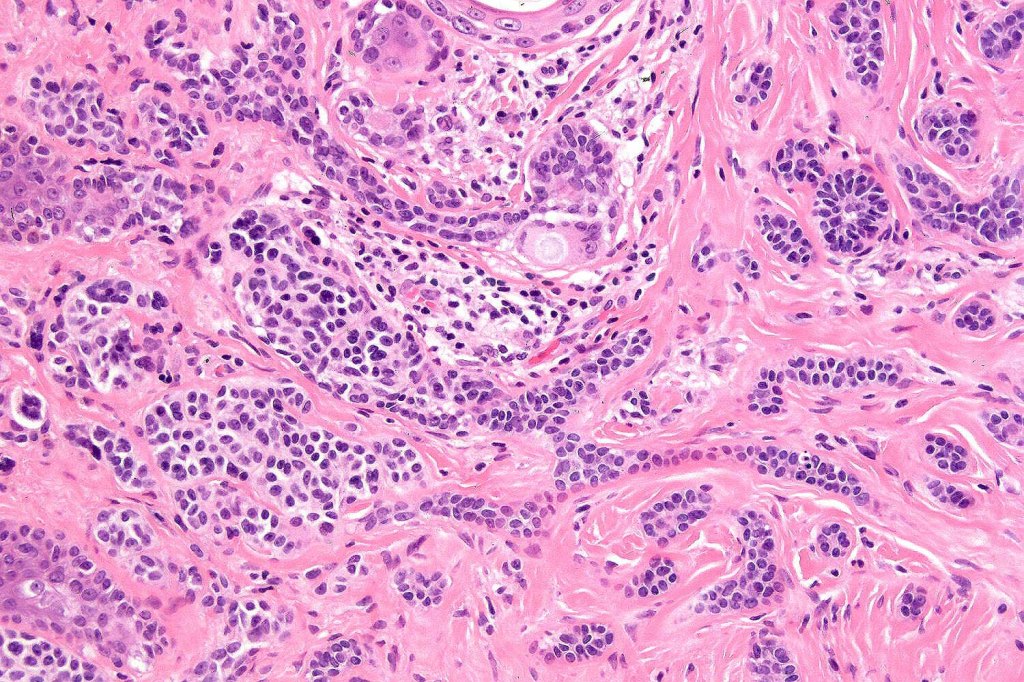
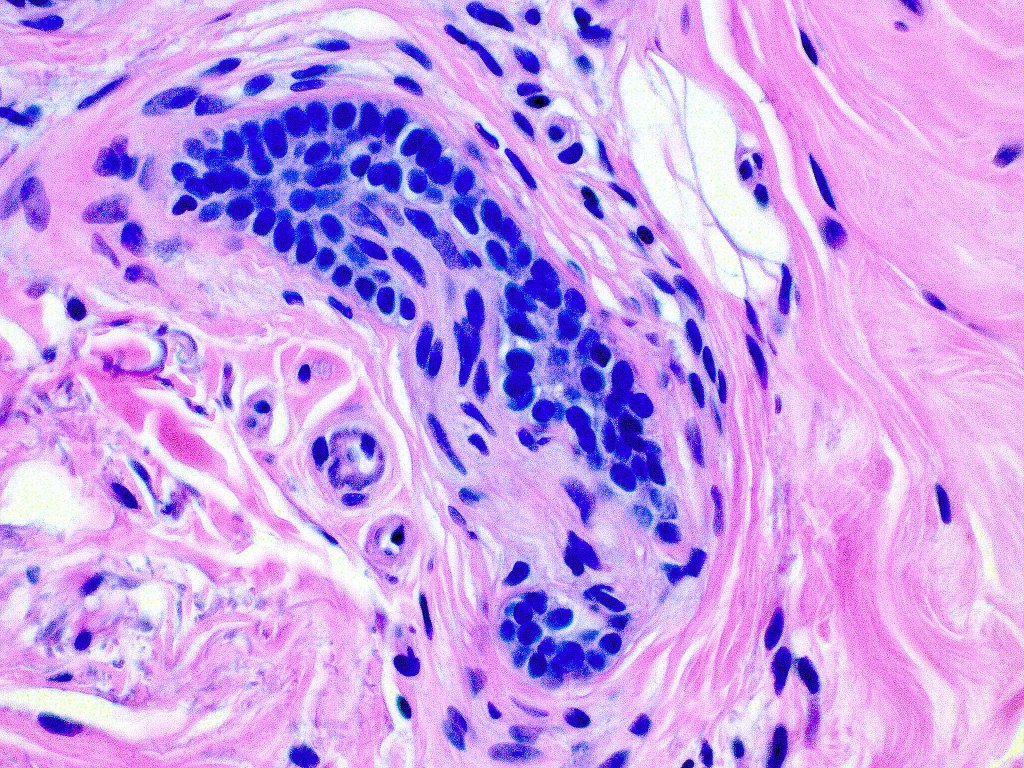

Clinical features
•Asymptomatic, slowly growing less than 1.0 cm white or yellow lesion with a predilection for the cheek, chin & forehead
•Lesions are indurated and the extent is difficult to delineate clinically similar to microcystic adnexal carcinoma)
•Asymptomatic
•Does not ulcerate
•Rarely multiple
•Often associated with a central dell
.4F=1M
Histological features
•Consists of narrow epithelial strands & keratocysts embedded in a dense stroma
•Generally involves superficial & mid dermis but does not extend into the subcutaneous fat
•No evidence of glandular differentiation
•Calcification, foreign body giant cell reaction to keratin & bone are inconstant findings
•Epithelial stands may arise from follicular epithelium
•Can rarely see matricial differentiation
•CK20 highlights Merkel cells
•Perineural infiltration is documented but is exceptional & makes differentiation from MAC difficult
•Co-existence with a dermal nevus is sometimes encountered
. EMA & CEA show no evidence of ductal differentiation

Leave a comment